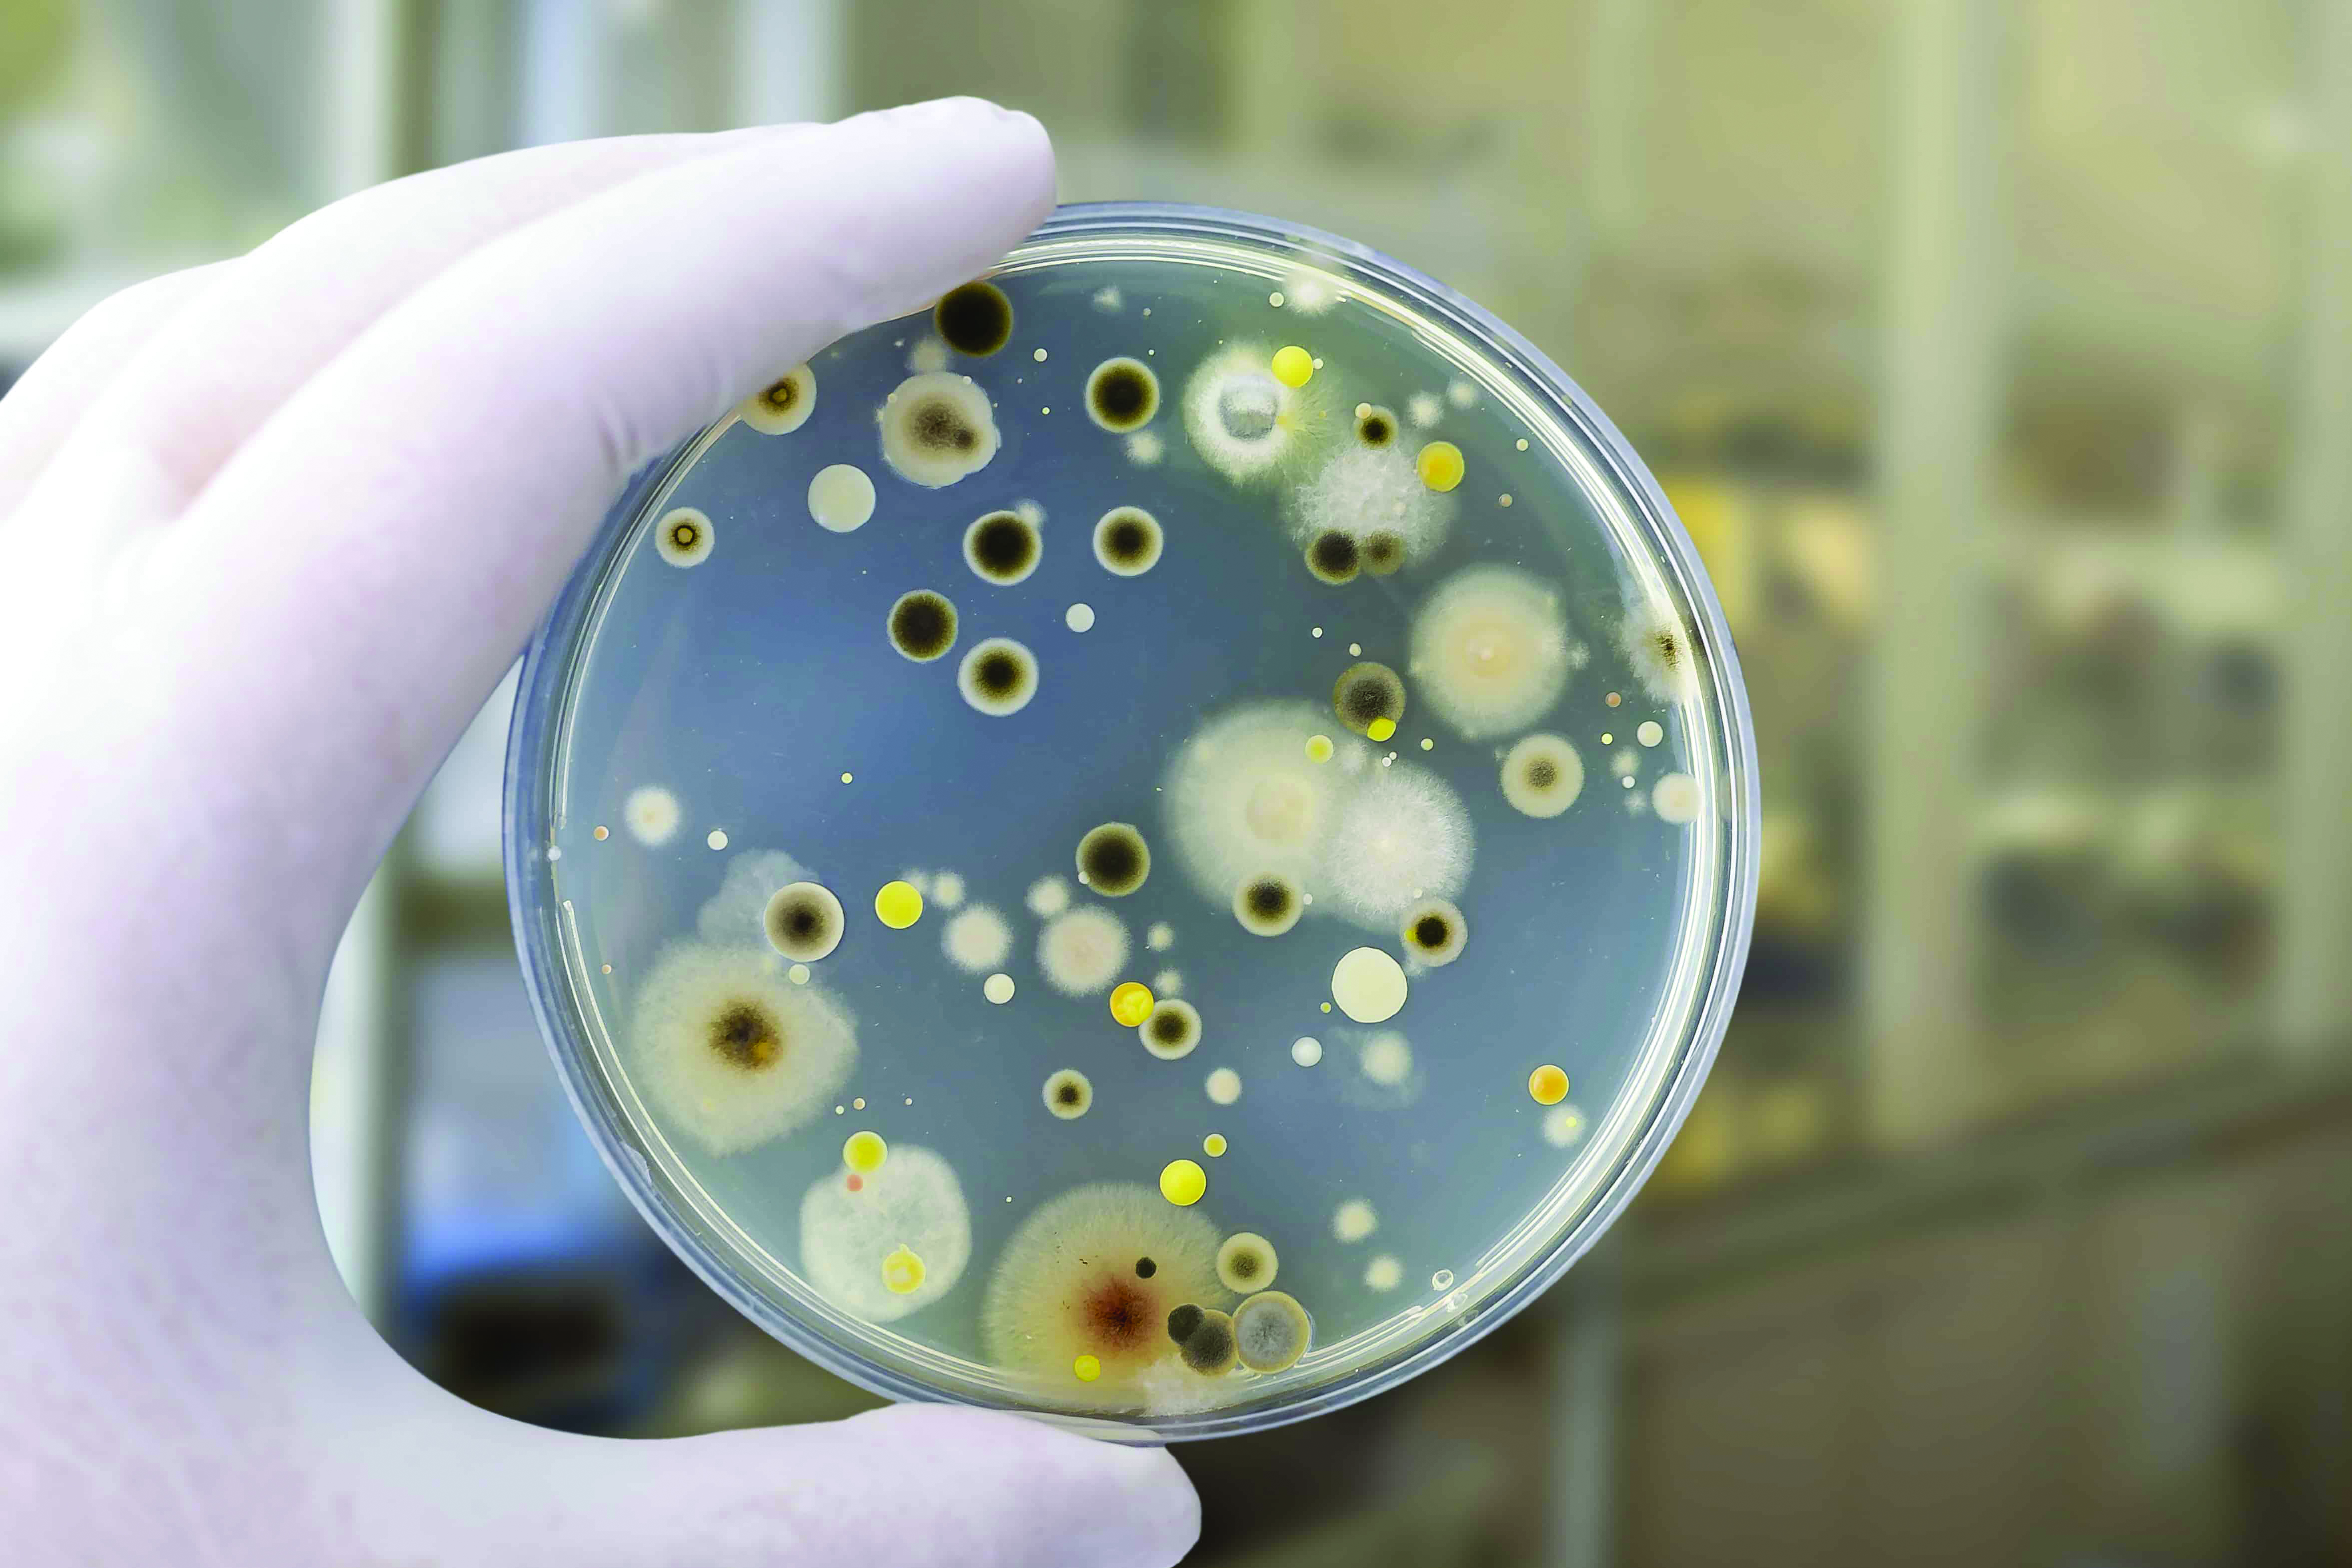
FUNGUS

TRTEST Test ve Değerlendirme A.Ş. aims to meet the test needs of the entire local manufacturers, led by the defense industry, and to become the independent and reliable test authority acting on behalf of the public authorities. Making sure that Turkish Armed Forces operates its services with the “Most Reliable Products” under the achievement made for the tests of Advanced Technology / Added Value products is the is to make sure that service approach of TRTEST Test ve Değerlendirme A.Ş. The company’s future objective is to carry out its current test functions by means of the locally produced devices and to own the Library of Optimized Procedures within the know-how gained.

Ballistic Tests are conducted in the relevant caliber and for the armed attacks in the relevant distance in order to determine if the bullet penetrated into the safe zone - through door, window, panel, plate, vest, helmet, glass or curtain wall - directly or indirectly and provided protection and to establish the degree of protection.

The following tests are carried out for land vehicles, especially ballistic and Mine/IED tests. • Ballistic, Mine IED Tests (Survivability) • Mobility and Performance Tests • Environmental Tests

EMI Tests are conducted to control the harmful transmissions, operating frequency, and output powers of the devices running on the radio frequency waves. The test determines if the device gives rise to any electromagnetic interference in the respective environment In EMC Tests, a system or a device is tested to clarify if it operates without the impact on the other systems and devices present in the same environment. As a result of the test, an analysis is made if the device has an impact on the other devices’ functions or performances due to the electromagnetic noises or impacts generated and emitted to the environment by it.
Fungus Test is conducted to determine if fungi will reproduce in the important civilian and military equipment under controlled environmental conditions and, where they reproduce, if such a reproduction has an impact on the equipment’s functionality. The accredited test activities for air, land, marine platforms and subcomponents thereof, electric and electronic devices and mechanical parts thereof, sensors, textile and textile products, plastic and plastic products, any and all packaging materials, paper and paper products, cables, rubber and glass products, paints, painted surfaces and protective layers, ceramic and ceramic products, wood and wood products, metal and metal products, and petroleum products are conducted at our laboratories

Cyber Security Penetration tests include the analysis of the identified system/product in terms of security, security vulnerabilities and security gaps, and penetration into systems / products by exploiting these gaps. Thanks to the Cyber Security Penetration tests, vulnerabilities and weaknesses in an organization’s product/ network and system infrastructure can be determined in advance. This prevents malicious hackers or an employee in the organization from damaging these systems. By the way, The tests is done within the framework of criteria established for cyber security products family such as Firewall, SIEM, DLP, Endpoint Security, Threat Intelligence.

Defense Industry Agency has made it mandatory to obtain Cyber Hygiene Certificate, which is issued by “TRTEST Test ve Değerlendirme A.Ş” , in order to be part of the SAV.NET. For Cyber Hygiene Certification Program, Cyber Hygiene Urgent Measures Set and test methologies are developed under 4 main categories, based on National and International studies with partnership of Turkish Cyber Security Cluster member companies under the leadership of TRTEST.

Program consists of technical examination of registered domestic products, systems sub-systems and components under SSB Talent Inventory Portal ("YETEN") , preparation of technical reference documents while defining the tests and performance measurements according to standarts and methods, evaluation and documentation according to reference document.

Our facility located in Kalecik can support the test flights of UAVs designed in Turkey with an allocated TRTEST airspace of 3.7km width and 48km up to an average of 7000 feet. Within the 80,000 m2 of fenced and controlled area, there are 5 buildings consisting of 10 independent workshops providing groud support services and social needs. Our facility also includes 10 meter wide apron area, 200 meter long runway and 25*25 helipad

In the laboratory, hydrodynamic and hydroacoustic examinations and performance tests of the underwater vehicles, such as torpedoes and submarines, and underwater dynamic components of surface vehicles, such as propellers, can be carried out. Considering the amount of flow in the test section, it is the 7th largest infrastructure in the world among its equivalents and tests can be carried out at speeds up to 16m/s at the tunnel.

TURQUM® is a program designed to help machinery manufacturers in the machinery sector who are active in export and aim to gain a advantage at both national and international level and contribute to the economy of scale by inspecting and documenting the adequacy of the manufacturing system, quality management system, product safety and quality system of these companies with sample question sets so that they can be easily recognized as a reliable supplier by customers in domestic and foreign markets.